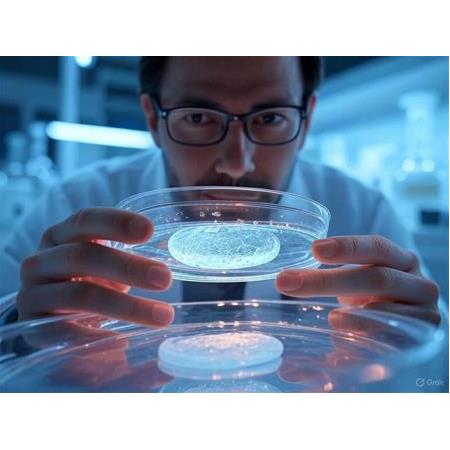
Molibden Disülfür (MoS²) Sol-Jel kaplama Nasıl Yapılır?

Molibden Disülfür (MoS²), lameller yapısı sayesinde düşük sürtünme katsayısı, yüksek sıcaklık dayanımı ve elektriksel iletkenliği ile bilinir. Sol-Jel yöntemiyle mikron boyuttaki MoS² tozlarının kaplama malzemesine dönüştürülmesi, yüksek performanslı yüzey uygulamaları için son derece avantajlıdır. Bu yöntem sayesinde homojen, kontrollü kalınlığa sahip ve yüksek dayanımlı filmler üretilebilir.
Molibden Disülfür (MoS²) mikron tozu (1–10 µm)
Sol öncül bileşeni: Tetraetil ortosilikat (TEOS) veya titanyum izopropoksit
Çözücü: Etanol veya izopropanol
Katalizör: Asetik asit (asit katalizi için) veya amonyak (bazik ortam)
İsteğe bağlı katkılar: Grafen, silika, zirkonya gibi destek malzemeleri
MoS² mikron tozu, çözücü içinde ultrasonik banyo kullanılarak tamamen dağıtılır (yaklaşık 30–60 dakika).
TEOS veya başka bir metal alkoksit çözücüye eklenir, ardından kontrollü miktarda su ve katalizör eklenerek hidroliz ve kondenzasyon başlatılır.
Karışım homojen bir sol haline getirilir ve 12–24 saat yaşlandırılarak jelleşme süreci tamamlanır.
Karışım, istenen yüzeye uygun teknikle kaplanmaya hazır hale gelir.
Dip Coating: Yavaş ve kontrollü çekimle kalın film elde edilir.
Spin Coating: Tekdüze ince filmler ve sensör uygulamaları için uygundur.
Spray Coating: Geniş yüzeylerde seri üretim uygulamaları için idealdir.
Kurulama: 80–120?°C'de çözücülerin uzaklaştırılması sağlanır.
Kürleme: 300–500?°C'de kontrollü ısıl işlem uygulanır. Bu sıcaklık, MoS²'nin kristal yapısını koruyacak şekilde seçilmelidir.
İsteğe bağlı olarak argon veya azot atmosferinde sinterleme yapılabilir.
Düşük sürtünme katsayısı (tribolojik performans)
Elektriksel iletkenlik
Korozyon direnci
Termal stabilite
Katmanlı (lamellar) yapı avantajı
Yüzeye iyi yapışma
Aşınmaya karşı dayanım
Kuru yağlayıcı kaplamalar
Mikro-elektromekanik sistemler (MEMS)
Korozyon dirençli yüzeyler
Pil elektrotları ve enerji depolama cihazları
Yüksek sıcaklık rulman sistemleri
Sensör platformları ve biyomalzemeler